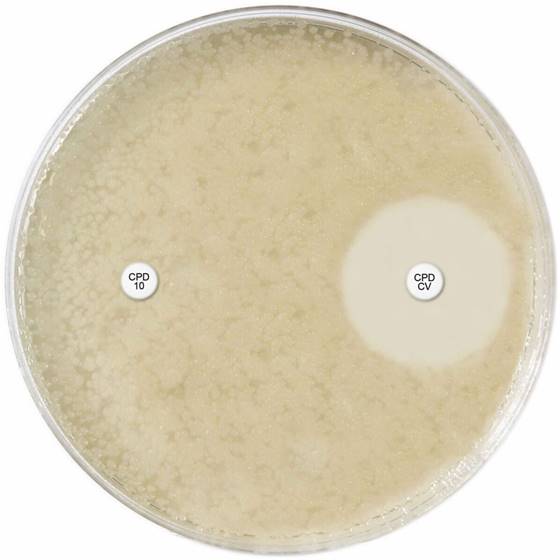
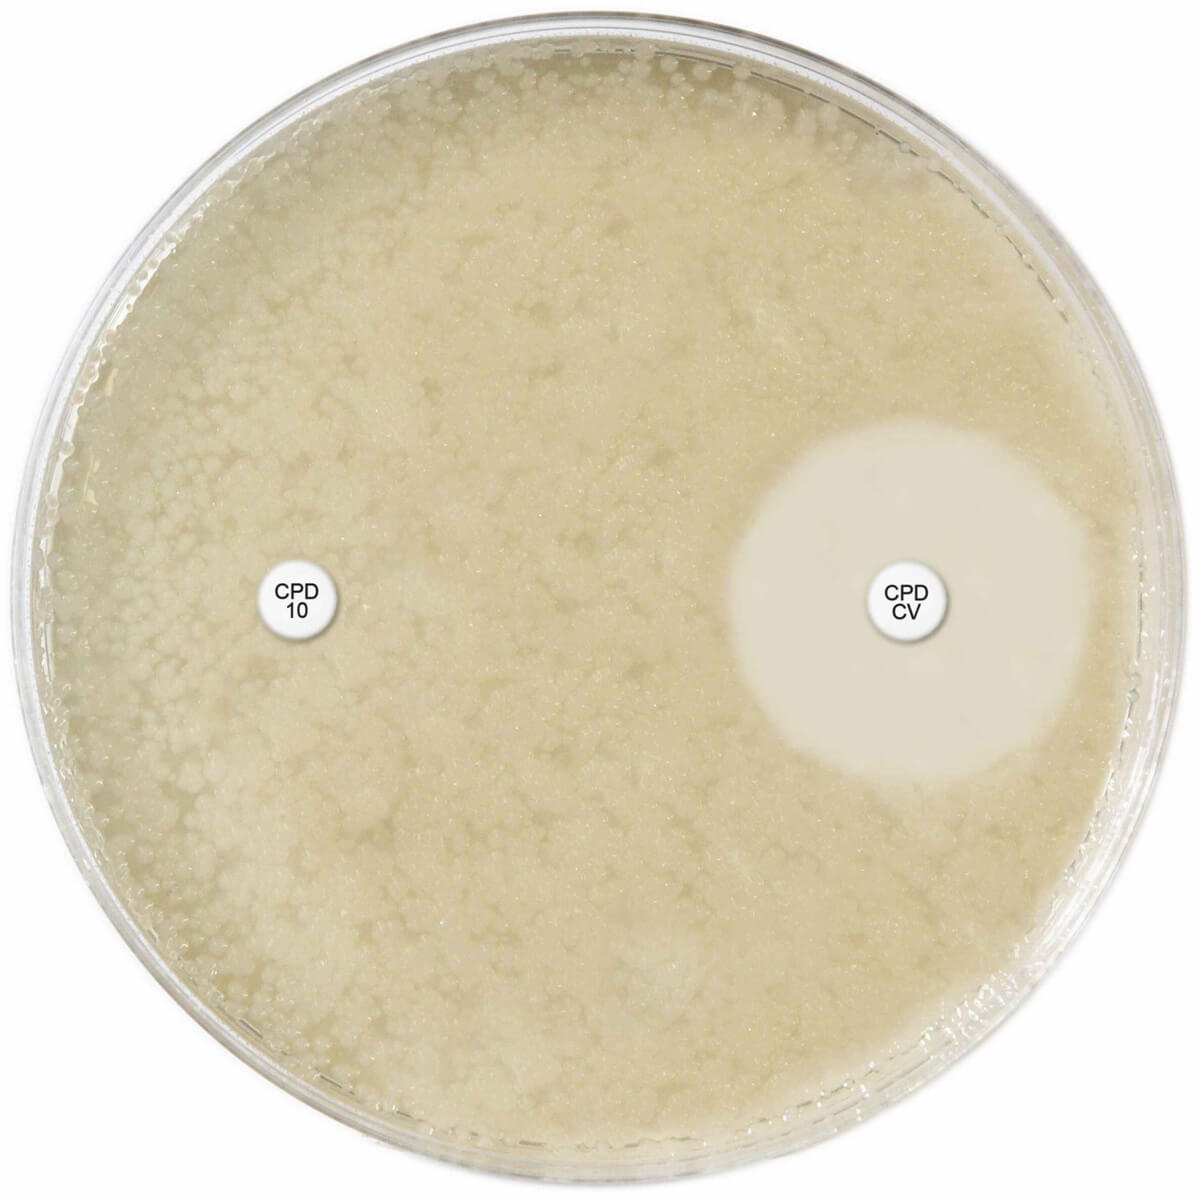
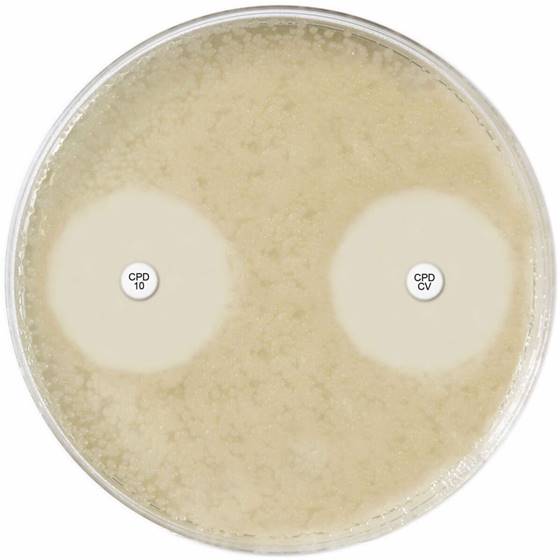

About the product
Three paired sets of cartridges for the detection of Extended Spectrum Beta-Lactamases:
- Cefpodoxime 10µg discs (x 3)
- Cefpodoxime 10µg discs + Clavulanic acid 1µg discs (x3)
CEFPODOXIME ESBL ID DISC SET

Three paired sets of cartridges for the detection of Extended Spectrum Beta-Lactamases: